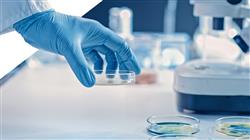
master genomic precision nutrition nursing Tech Universidad

Университетская квалификация
Крупнейший в мире факультет сестринского дела”
Презентация
Обновите свои знания и навыки ухода в области нутригеномики и прецизионного питания с помощью этой программы, которая включает интенсивную клиническую практику в ведущем медицинском учреждении”

В последние годы область нутригеномики и прецизионного питания значительно продвинулась благодаря многим научным и технологическим открытиям в этой сфере. На сегодняшний день разработаны более эффективные пищевые добавки и стратегии вмешательства и профилактики заболеваний, таких как гипертония или сахарный диабет II типа, основанные на взаимодействии определенных генов с конкретными питательными веществами. Для эффективного применения этих методик важно, чтобы специалисты сестринского дела обладали самыми актуальными знаниями и навыками в этой области.
В связи с этим TECH создал Очно-заочную магистратуру, направленную на изучение последних достижений в области нутригеномики и прецизионного питания. Используемая в данной программе образовательная методология является смешанной, поскольку сочетает теоретическое и практическое обучение со стажировкой в престижном центре. Так, первая часть обучения проходит на интерактивной платформе, на 100% в онлайн-режиме, с ценными мультимедийными ресурсами, такими как инфографики и видеоматериалы. Кроме того, используются инновационные методологии, такие как Relearning, что облегчает понимание сложных концепций.
После теоретического этапа TECH предлагает клиническую практику продолжительностью 120 часов в ведущей больнице. В течение этого периода студенты будут применять полученные теоретические знания на реальных пациентах в самых сложных клинических условиях. Для обеспечения правильного применения этих методик каждому студенту назначается куратор, который будет оказывать поддержку в любой момент. Практическая стажировка длится три недели с рабочим днем продолжительностью 8 часов. В конце обучения студенты будут готовы применять основные инновации в области нутригеномики и прецизионного питания в своей повседневной практике в области сестринского дела.
Овладейте самыми современными процедурами в области нутригеномики благодаря данной Профессиональной магистерской специализации, с помощью которой вы сможете применить на практике новейшие методики консультирования по вопросам питания"
Данная Очно-заочная магистратура в области нутригеномики и прецизионного питания для сестринского дела содержит самую полную и современную научную программу на рынке.
Основными особенностями обучения являются:
- Разбор более 100 клинических случаев, представленных экспертами в области нутригеномики и персонализированного питания
- Наглядное, схематичное и исключительно практическое содержание программы предоставляет научную и фактическую информацию по тем дисциплинам, которые необходимы для осуществления профессиональной деятельности
- Интерактивная обучающая система, основанная на алгоритмах принятия решения в созданных клинических ситуациях
- Практическое руководство по клинической практике в области диагностики при различных патологиях в области нутригеномики
- Все вышеперечисленное дополняют теоретические занятия, вопросы к эксперту, дискуссионные форумы по спорным вопросам и индивидуальная работа по закреплению материала
- Доступ к учебным материалам с любого стационарного или мобильного устройства с выходом в интернет
- Кроме того, вы сможете пройти клиническую практику в одной из лучших больниц
TECH тщательно отобрал самые престижные учебные центры, чтобы вы могли обучаться в клинической среде высокого уровня"
В данной Магистратуре, имеющей профессионально-ориентированный характер и очно-заочную форму обучения, программа направлена на обновление знаний специалистов сестринского дела, которым требуется высокий уровень квалификации. Содержание основано на последних научных данных и ориентировано в дидактической форме на интеграцию теоретических знаний в сестринскую практику, а теоретико-практические элементы будут способствовать обновлению знаний и позволят принимать решения по ведению пациентов.
Мультимедийное содержание программы, разработанное с использованием новейших образовательных технологий, позволит специалисту проходить обучение с учетом контекста и ситуации, т. е. в симулированной среде, обеспечивающей иммерсивный учебный процесс, запрограммированный на обучение в реальных ситуациях. Структура этой программы основана на проблемно-ориентированном обучении, с помощью которого специалист должен попытаться решить различные ситуации из профессиональной практики, возникающие в течение учебного курса. В этом специалисту будет помогать инновационная система интерактивных видеоматериалов, созданная признанными и опытными экспертами.
Получите современные знания, чтобы быть в авангарде персонализированной медицинской помощи и уметь разрабатывать специальные планы по питанию для каждого пациента"

Очно-заочная форма обучения позволит вам учиться в удобном для вас темпе и на 100% в онлайн-формате, а затем применить полученные знания в престижном центре"
Зачем брать эту смешанную степень магистра?
В сфере сестринского дела практическое применение знаний имеет ключевое значение для правильной клинической работы. TECH осознает эту потребность и предлагает Очно-заочную магистратуру, которая сочетает теоретическое онлайн-обучение с непосредственным и иммерсивным опытом. Данная программа продолжительностью 1620 часов дает специалистам сестринского дела возможность приобрести практические навыки высшего уровня и овладеть наиболее инновационными понятиями и инструментами в области нутригеномики и прецизионного питания.
Запишитесь и воспользуйтесь уникальной возможностью профессионального обновления с TECH”
1. Обновить свои знания благодаря новейшим доступным технологиям
В последние годы клинические и лабораторные исследования в области нутригеномики и прецизионного питания значительно продвинулись благодаря научно-технологическому прогрессу. Данная программа предоставляет специалистам сестринского дела доступ к этим инновационным инструментам, позволяя применять их при диагностике и лечении пациентов для улучшения качества медицинского ухода.
2. Глубоко погрузиться в обучение, опираясь на опыт лучших специалистов
На протяжении всего обучения специалиста сестринского дела будут поддерживать эксперты и персональные наставники. Во время теоретического этапа выдающийся преподавательский состав будет готов разъяснить все сомнения и помочь в понимании ключевых концепций. Во второй половине программы назначенный наставник будет контролировать и направлять учащегося в процессе обучения.
3. Попасть в первоклассную клиническую среду
TECH тщательно отбирает все доступные медицинские центры для Практической подготовки. Благодаря этому, специалист получит гарантированный доступ к престижной клинической среде в области нутригеномики. Таким образом, студент сможет увидеть повседневную работу в требовательной, строгой и изнурительной области, всегда применяющей новейшие научные тезисы и постулаты в своей рабочей методологии.
4. Объединить лучшую теорию с самой передовой практикой
Для того, чтобы получить полное профессиональное обновление в области нутригеномики и прецизионного питания, TECH разработал учебную программу, сочетающую теорию и практику. Подход сосредоточен на очном и интенсивном опыте, который позволяет специалистам сестринского дела полностью погрузиться в дисциплину, предоставляя им полное и актуальное обновление знаний в этой области.
5. Расширять границы знаний
TECH предлагает возможность прохождения Практической подготовки в международных центрах. Таким образом, специалист сможет расширить свои границы и приблизиться к лучшим профессионалам, практикующим в первоклассных больницах на разных континентах. Уникальная возможность, которую может предложить только TECH, крупнейший в мире цифровой университет.

У вас будет полное практическое погружение в выбранном вами медицинском центре"
Очно-заочной магистратуры в области нутригеномики и прецизионного питания для сестринского дела
В рамках Магистратуры в области клинического питания в педиатрии для сестринского дела вы также научитесь интерпретировать результаты диагностических тестов и работать в команде с другими медицинскими специалистами, такими как врачи, нутрициологи и диетологи. Благодаря нашей очно-заочной методологии, вы сможете совмещать обучение с личной жизнью и работой. Станьте экспертом в области детского питания и внесите свой вклад в уход и улучшение здоровья детей.